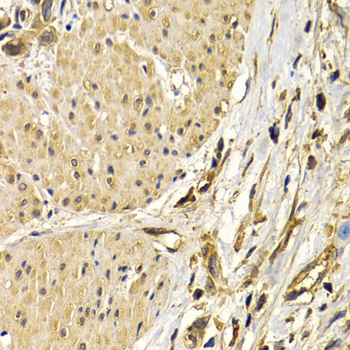
A1057: image 3

For quotations, please use our online quotation form, and you may also contact us by
sales@neoscientific.com
+1-888.733.6849
+1-617.299.7367 (Int’l)
+1-888.733.6849
+1-617.299.7367 (Int’l)
| Reactivity | Human Mouse Rat |
| Tested applications | WB IHC IF |
| Recommended Dilution | WB 1:500 - 1:2000 IHC 1:50 - 1:200 IF 1:50 - 1:200 |
| Calculated MW | 30kDa |
| Observed MW | Refer to Figures |
| Immunogen | Recombinant protein of human SNAI2 |
| Storage Buffer | Store at -20℃. Avoid freeze / thaw cycles. Buffer: PBS with 0.02% sodium azide, 50% glycerol, pH7.3. |
| Concentration | k |
| Synonym | SNAI2;MGC10182;SLUG;SLUGH1;WS2D ; |

Western blot analysis of pancreas cell lysate using SNAI2 antibody.

Immunohistochemistry of paraffin-embedded human lung cancer using SNAI2 antibody at dilution of 1:200 (400x lens).
Immunohistochemistry of paraffin-embedded human stomach cancer using SNAI2 antibody at dilution of 1:200 (400x lens).

Immunohistochemistry of paraffin-embedded Human liver injury using SNAI2 antibody at dilution of 1:100 (x400 lens).

Immunohistochemistry of paraffin-embedded Human liver injury using SNAI2 antibody at dilution of 1:100 (x400 lens).

Immunofluorescence analysis of MCF7 cell using SNAI2 antibody. Blue: DAPI for nuclear staining.

Immunofluorescence analysis of U2OS cell using SNAI2 antibody. Blue: DAPI for nuclear staining.

Immunofluorescence analysis of A549 cell using SNAI2 antibody. Blue: DAPI for nuclear staining.

Immunofluorescence analysis of A549 cell using SNAI2 antibody.
Slug (SNAI2) is a widely expressed transcriptional repressor and member of the Snail family of zinc finger transcription factors (1). Similar to the related Snail protein, Slug binds to the E-cadherin promoter region to repress transcription during development (2). The binding of Slug to integrin promoter sequences represses integrin expression and results in reduced cell adhesion (3). Down regulation of E-cadherin expression occurs during the epithelial-mesenchymal transition during embryonic development, a process also exploited by invasive cancer cells (4,5). The tumor suppressor protein p53 induces Slug expression in γ-irradiated cells; Slug protects damaged cells from apoptosis by repressing p53-induced transcription of the proapoptotic Bcl-2 family protein Puma (6). Deletion mutations in the corresponding Slug gene are associated with the pigmentation disorders Waardenburg Syndrome and Piebaldism, while a genetic duplication resulting in Slug overexpression is associated with a collection of congenital heart defects termed tetralogy of Fallot (7).
N/A